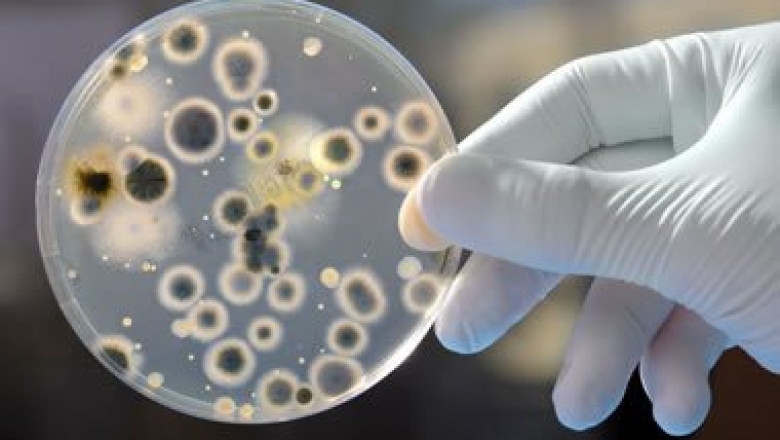
Legionella testing

201
views
views
Legionella screening is necessary, which is why you will want to make one of the most from your demands to begin with. If you are seeking the best means to go and need all the aid viable to make ti job like it should, do not wait to look into the official website asap.












